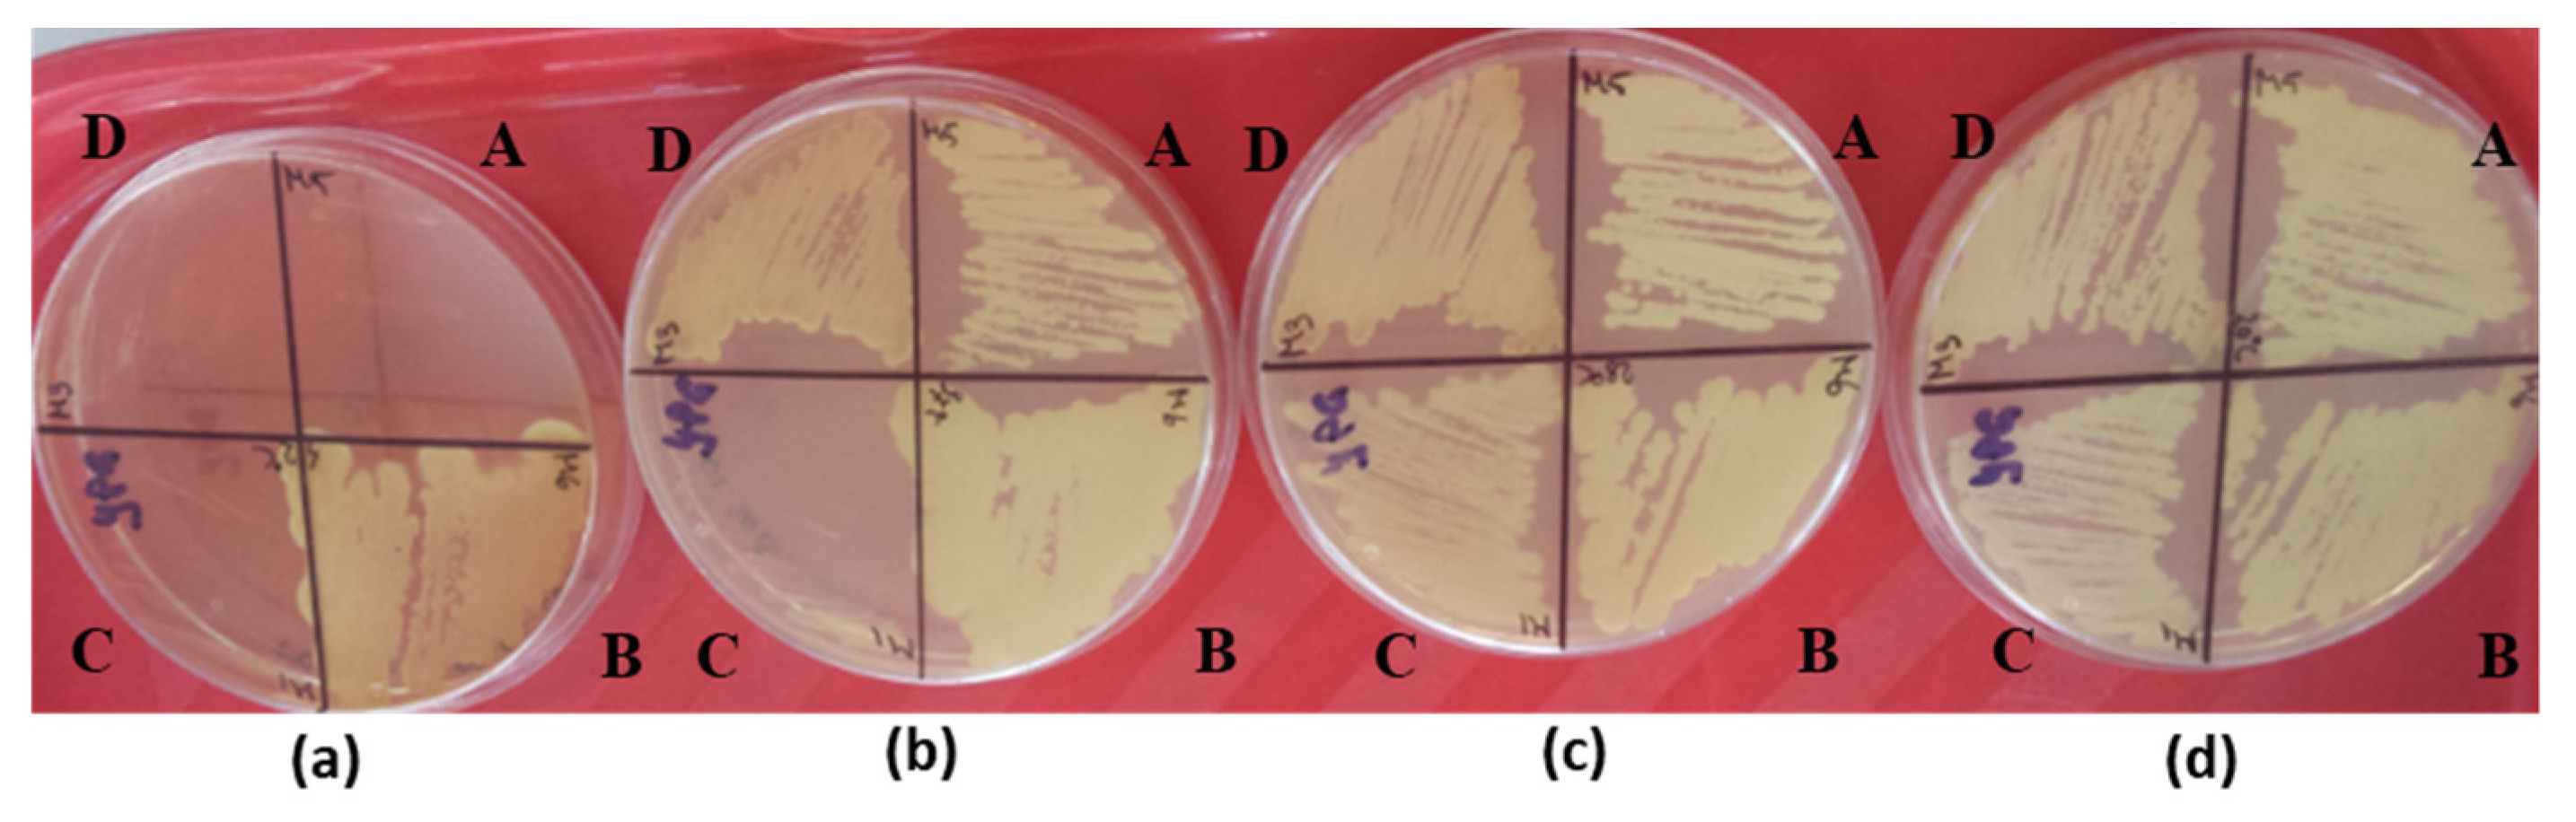
Microorganisms 11 00037 g003 Microorganisms 11 00037 g003

Molecular and Physiological Diversity of Indigenous Yeasts Isolated from Spontaneously Fermented Wine Wort from Ilfov County, Romania
Abstract
1. Introduction
2. Materials and Methods
2.1. Biological Material
2.2. Conventional Taxonomy Tests
2.3. Taxonomic Identification Using Automated Systems
2.4. Molecular Taxonomy Tests
2.4.1. Genomic DNA Isolation
2.4.2. PCR-RFLP and Sequencing of the ITS1-5.8S rDNA-ITS2 Region
2.5. Cell Growth under Stress Conditions
2.6. Confirmation of Safe Status—Determination of Virulence and Pathogenicity Factors
2.6.1. Production of Hydrolytic Enzymes
2.6.2. Dimorphism Switching Assays
2.6.3. Evaluation of the Adhesion Capacity to Inert Substrate
2.7. Qualitative Screening of Antimicrobial Activity
2.7.1. Substrate Competition Assays
2.7.2. Activity at Low pH Values
2.8. Statistical Analysis
3. Results and Discussions
3.1. Taxonomic Identification
3.2. Characterization of Industrial and Biotechnological Potential
3.2.1. Growth under Stress Conditions
Influence of Thermal Stress
Influence of Osmotic Stress
Influence of Different pH Values
3.2.2. Confirmation of Safety Status; Synthesis of Virulence and Pathogenicity Factors
3.3. Mechanisms of Antimicrobial Activity against Candida Strains
3.3.1. Competition for Nutritive Substrates
3.3.2. Synthesis of Killer Toxins
4. Conclusions
Supplementary Materials
Author Contributions
Funding
Data Availability Statement
Conflicts of Interest
References
- Camilo, S.; Chandra, M.; Branco, P.; Malfeito-Ferreira, M. Wine Microbial Consortium: Seasonal Sources and Vectors Linking Vineyard and Winery Environments. Fermentation 2022, 8, 324. [Google Scholar] [CrossRef]
- Cioch-Skoneczny, M.; Satora, P.; Skoneczny, S.; Pater, A. Determination of the Oenological Properties of Yeast Strains Isolated from Spontaneously Fermented Grape Musts Obtained from Cool Climate Grape Varieties. Eur. Food Res. Technol. 2020, 246, 2299–2307. [Google Scholar] [CrossRef]
- Capozzi, V.; Garofalo, C.; Chiriatti, M.A.; Grieco, F.; Spano, G. Microbial Terroir and Food Innovation: The Case of Yeast Biodiversity in Wine. Microbiol. Res. 2015, 181, 75–83. [Google Scholar] [CrossRef] [PubMed]
- Roullier-Gall, C.; David, V.; Hemmler, D.; Schmitt-Kopplin, P.; Alexandre, H. Exploring Yeast Interactions through Metabolic Profiling. Sci. Rep. 2020, 10, 6073. [Google Scholar] [CrossRef]
- Zhang, B.Q.; Luan, Y.; Duan, C.Q.; Yan, G.L. Use of Torulaspora delbrueckii Co-Fermentation with Two Saccharomyces cerevisiae Strains with Different Aromatic Characteristic to Improve the Diversity of Red Wine Aroma Profile. Front. Microbiol. 2018, 9, 606. [Google Scholar] [CrossRef]
- Roudil, L.; Russo, P.; Berbegal, C.; Albertin, W.; Spano, G.; Capozzi, V. Non-Saccharomyces Commercial Starter Cultures: Scientific Trends, Recent Patents and Innovation in the Wine Sector. Recent Pat. Food. Nutr. Agric. 2019, 11, 27–39. [Google Scholar] [CrossRef]
- Ramírez, M.; Velázquez, R. The Yeast Torulaspora delbrueckii: An Interesting but Difficult-To-Use Tool for Winemaking. Fermentation 2018, 4, 94. [Google Scholar] [CrossRef]
- Gonzalez, R.; Morales, P. Truth in Wine Yeast. Microb. Biotechnol. 2022, 15, 1339–1356. [Google Scholar] [CrossRef]
- Martin, V.; Jose Valera, M.; Medina, K.; Boido, E.; Carrau, F. Oenological Impact of the Hanseniaspora/Kloeckera Yeast Genus on Wines—A Review. Fermentation 2018, 4, 76. [Google Scholar] [CrossRef]
- Medina, K.; Boido, E.; Fariña, L.; Gioia, O.; Gomez, M.E.; Barquet, M.; Gaggero, C.; Dellacassa, E.; Carrau, F. Increased Flavour Diversity of Chardonnay Wines by Spontaneous Fermentation and Co-Fermentation with Hanseniaspora vineae. Food Chem. 2013, 141, 2513–2521. [Google Scholar] [CrossRef]
- Medved’ová, A.; Šipošová, P.; Mančušková, T.; Valík, L. The Effect of Salt and Temperature on the Growth of Fresco Culture. Fermentation 2018, 5, 2. [Google Scholar] [CrossRef]
- Nonklang, S.; Abdel-Banat, B.M.A.; Cha-aim, K.; Moonjai, N.; Hoshida, H.; Limtong, S.; Yamada, M.; Akada, R. High-Temperature Ethanol Fermentation and Transformation with Linear DNA in the Thermotolerant Yeast Kluyveromyces marxianus DMKU3-1042. Appl. Environ. Microbiol. 2008, 74, 7514–7521. [Google Scholar] [CrossRef]
- Guan, N.; Li, J.; Shin, H.-d.; Du, G.; Chen, J.; Liu, L. Microbial Response to Environmental Stresses: From Fundamental Mechanisms to Practical Applications. Appl. Microbiol. Biotechnol. 2017, 101, 3991–4008. [Google Scholar] [CrossRef] [PubMed]
- Serra-Cardona, A.; Canadell, D.; Ariño, J. Coordinate Responses to Alkaline PH Stress in Budding Yeast. Microb. Cell 2015, 2, 182. [Google Scholar] [CrossRef] [PubMed]
- Gostinčar, C.; Zajc, J.; Lenassi, M.; Plemenitaš, A.; de Hoog, S.; Al-Hatmi, A.M.S.; Gunde-Cimerman, N. Fungi between Extremotolerance and Opportunistic Pathogenicity on Humans. Fungal Divers. 2018, 93, 195–213. [Google Scholar] [CrossRef]
- Feutry, F.; Oneca, M.; Berthier, F.; Torre, P. Biodiversity and Growth Dynamics of Lactic Acid Bacteria in Artisanal PDO Ossau-Iraty Cheeses Made from Raw Ewe’s Milk with Different Starters. Food Microbiol. 2012, 29, 33–42. [Google Scholar] [CrossRef] [PubMed]
- Liu, Y.; Yao, S.; Deng, L.; Ming, J.; Zeng, K. Different Mechanisms of Action of Isolated Epiphytic Yeasts against Penicillium digitatum and Penicillium italicum on Citrus Fruit. Postharvest Biol. Technol. 2019, 152, 100–110. [Google Scholar] [CrossRef]
- Kurtzman, C.P.; Fell, J.W.; Boekhout, T. The Yeasts: A Taxonomic Study; Elsevier: Amsterdam, The Netherlands, 2011. [Google Scholar]
- Vassu, T.; Csutak, O.; Musat, F.; Stoica, I. Genetica Microorganismelor Și Inginerie Microbiană; Petrion: Bucharest, Romania, 2002. [Google Scholar]
- Barnett, J.A.; Payne, W.; Yarrow, D. Yeasts: Characteristics and Identification; Cambridge University Press: Cambridge, UK, 1983. [Google Scholar]
- Corbu, V.; Csutak, O. Biodiversity studies on Pichia kudriavzevii from romanian spontaneous fermented products. AgroLife Sci. J. 2020, 9, 104–114. [Google Scholar]
- Ionescu, D.; Chifiriuc, M.C.; Ionescu, B.; Cristea, V.C.; Sacagiu, B.; Duta, M.; Neacsu, G.; Gilca, R.; Bleotu, C.; Bezirtzoglu, E.; et al. Frequency and Phenotypic Virulence Features of Streptococcus pyogenes Strains Isolated from Throat Carriage in Romanian Population. Romanian Biotechnol. Lett. 2015, 20, 10470–10477. [Google Scholar]
- Álvarez-Buylla, A.; Culebras, E.; Picazo, J.J. Identification of Acinetobacter Species: Is Bruker Biotyper MALDI-TOF Mass Spectrometry a Good Alternative to Molecular Techniques? Infect. Genet. Evol. 2012, 12, 345–349. [Google Scholar] [CrossRef]
- Csutak, O.; Vassu, T. Phylogenetic Analysis and Characterization of an Alkane-Degrading Yeast Strain Isolated from Oil-Polluted Soil. Turk. J. Biol. 2014, 38, 601–610. [Google Scholar] [CrossRef]
- Pavel, A.B.; Vasile, C.I. PyElph—A Software Tool for Gel Images Analysis and Phylogenetics. BMC Bioinform. 2012, 13, 9. [Google Scholar] [CrossRef] [PubMed]
- DNA Dragon: DNA Sequence Contig Assembly Software. Available online: https://www.dna-dragon.com/ (accessed on 6 November 2022).
- BLAST: Basic Local Alignment Search Tool. Available online: https://blast.ncbi.nlm.nih.gov/Blast.cgi (accessed on 6 November 2022).
- Corbu, V.; Petrut, S.; Vassu, T.; Pelinescu, D.; Sarbu, I.; Rusu, E.; Csutak, O. Environmental Stress Responses in Yeasts and Lactic Acid Bacteria Strains Isolated from Dairy Traditional Romanian Fermented Products. Rom. Biotechnol. Lett. 2021, 26, 2548–2559. [Google Scholar] [CrossRef]
- Zajc, J.; Gostinčar, C.; Černoša, A.; Gunde-Cimerman, N. Stress-Tolerant Yeasts: Opportunistic Pathogenicity Versus Biocontrol Potential. Genes 2019, 10, 42. [Google Scholar] [CrossRef] [PubMed]
- Sârbu, I.; Pelinescu, D.; Stoica, I.; Marutescu, L.; Vassu, T. Phenotypic profiles of virulence in different Candida species isolated from vulvovaginal infections. Romanian Arch. Microbiol. Immunol. 2013, 72, 225–233. [Google Scholar]
- Jin, Y.; Yip, H.K.; Samaranayake, Y.H.; Yau, J.Y.; Samaranayake, L.P. Biofilm-Forming Ability of Candida albicans Is Unlikely to Contribute to High Levels of Oral Yeast Carriage in Cases of Human Immunodeficiency Virus Infection. J. Clin. Microbiol. 2003, 41, 2961. [Google Scholar] [CrossRef]
- Csutak, O.; Vassu, T.; Sarbu, I.; Stoica, I.; Cornea, P. Antagonistic Activity of Three Newly Isolated Yeast Strains from the Surface of Fruits. Food Technol. Biotechnol. 2013, 51, 70–77. [Google Scholar]
- Csutak, O.; Cîrpici, I.; Ionescu, R.; Stoica, I.; Vassu, T. Anti-Candida Activity of Kluyveromyces lactis CMGB226 From Dairy Products. Innov. Rom. Food Biotechnol. 2015, 17, 46–56. [Google Scholar]
- López-González, M.J.; Escobedo, S.; Rodríguez, A.; Rute Neves, A.; Janzen, T.; Martínez, B. Adaptive Evolution of Industrial Lactococcus lactis under Cell Envelope Stress Provides Phenotypic Diversity. Front. Microbiol. 2018, 9, 2654. [Google Scholar] [CrossRef]
- Dufossé, L. Microbial Pigments from Bacteria, Yeasts, Fungi, and Microalgae for the Food and Feed Industries. In Natural and Artificial Flavoring Agents and Food Dyes; Academic Press: Cambridge, MA, USA, 2018; pp. 113–132. [Google Scholar] [CrossRef]
- Melvydas, V.; Bružauskaitė, I.; Gedminienė, G.; Šiekštelė, R. A Novel Saccharomyces cerevisiae Killer Strain Secreting the X Factor Related to Killer Activity and Inhibition of S. Cerevisiae K1, K2 and K28 Killer Toxins. Indian J. Microbiol. 2016, 56, 335. [Google Scholar] [CrossRef][Green Version]
- Péter, G.; Deák, T. On the False Positive Urease Activity of Yarrowia lipolytica. Antonie Van Leeuwenhoek 1991, 60, 55–59. [Google Scholar] [CrossRef] [PubMed]
- Zvyagilskaya, R.; Andreishcheva, E.; Soares, I.; Khozin, I.; Berhe, A.; Persson, B. Isolation and Characterization of a Novel Leaf-Inhabiting Yeast Strain. Growth 2001, 41, 289–303. [Google Scholar]
- Edwards-Ingram, L.; Gitsham, P.; Burton, N.; Warhurst, G.; Clarke, I.; Hoyle, D.; Oliver, S.G.; Stateva, L. Genotypic and Physiological Characterization of Saccharomyces boulardii, the Probiotic Strain of Saccharomyces cerevisiae. Appl. Environ. Microbiol. 2007, 73, 2458–2467. [Google Scholar] [CrossRef] [PubMed]
- Van der Aa Kühle, A.; Skovgaard, K.; Jespersen, L. In Vitro Screening of Probiotic Properties of Saccharomyces cerevisiae var. boulardii and Food-Borne Saccharomyces cerevisiae Strains. Int. J. Food Microbiol. 2005, 101, 29–39. [Google Scholar] [CrossRef]
- Pais, P.; Oliveira, J.; Almeida, V.; Yilmaz, M.; Monteiro, P.T.; Teixeira, M.C. Transcriptome-Wide Differences between Saccharomyces cerevisiae and Saccharomyces cerevisiae var. boulardii: Clues on Host Survival and Probiotic Activity Based on Promoter Sequence Variability. Genomics 2021, 113, 530–539. [Google Scholar] [CrossRef]
- Silva-Sousa, F.; Fernandes, T.; Pereira, F.; Rodrigues, D.; Rito, T.; Camarasa, C.; Franco-Duarte, R.; Sousa, M.J. Torulaspora delbrueckii Phenotypic and Metabolic Profiling towards Its Biotechnological Exploitation. J. Fungi 2022, 8, 569. [Google Scholar] [CrossRef]
- Guillamon, J.M.; Sabate, J.; Barrio, E.; Cano, J.; Querol, A. Rapid Identification of Wine Yeast Species Based on RFLP Analysis of the Ribosomal Internal Transcribed Spacer (ITS) Region. Arch. Microbiol. 1998, 169, 387–392. [Google Scholar] [CrossRef]
- Basílio, A.C.M.; De Araújo, P.R.L.; De Morais, J.O.F.; Da Silva Filho, E.A.; De Morais, M.A.; Simões, D.A. Detection and Identification of Wild Yeast Contaminants of the Industrial Fuel Ethanol Fermentation Process. Curr. Microbiol. 2008, 56, 322–326. [Google Scholar] [CrossRef]
- Bockelmann, W.; Heller, M.; Heller, K.J. Identification of Yeasts of Dairy Origin by Amplified Ribosomal DNA Restriction Analysis (ARDRA). Int. Dairy J. 2008, 18, 1066–1071. [Google Scholar] [CrossRef]
- Nisiotou, A.A.; Spiropoulos, A.E.; Nychas, G.J.E. Yeast Community Structures and Dynamics in Healthy and Botrytis-Affected Grape Must Fermentations. Appl. Environ. Microbiol. 2007, 73, 6705–6713. [Google Scholar] [CrossRef]
- Šuranská, H.; Vránová, D.; Omelková, J.; Vadkertiová, R. Monitoring of Yeast Population Isolated during Spontaneous Fermentation of Moravian Wine. Chem. Pap. 2012, 66, 861–868. [Google Scholar] [CrossRef]
- Las Heras-Vazquez, F.J.; Mingorance-Cazorla, L.; Clemente-Jimenez, J.M.; Rodriguez-Vico, F. Identification of Yeast Species from Orange Fruit and Juice by RFLP and Sequence Analysis of the 5.8 S RRNA Gene and the Two Internal Transcribed Spacers. FEMS Yeast Res. 2003, 3, 3–9. [Google Scholar] [CrossRef] [PubMed]
- Pham, T.; Wimalasena, T.; Box, W.G.; Koivuranta, K.; Storgårds, E.; Smart, K.A.; Gibson, B.R. Evaluation of ITS PCR and RFLP for Differentiation and Identification of Brewing Yeast and Brewery “wild” Yeast Contaminants. J. Inst. Brew. 2011, 117, 556–568. [Google Scholar] [CrossRef] [PubMed]
- Arroyo-López, F.N.; Durán-Quintana, M.C.; Ruiz-Barba, J.L.; Querol, A.; Garrido-Fernández, A. Use of Molecular Methods for the Identification of Yeast Associated with Table Olives. Food Microbiol. 2006, 23, 791–796. [Google Scholar] [CrossRef] [PubMed]
- Barbedo, L.S.; Figueiredo-Carvalho, M.H.G.; de Medeiros Muniz, M.; Zancopé-Oliveira, R.M. The Identification and Differentiation of the Candida parapsilosis Complex Species by Polymerase Chain Reaction-Restriction Fragment Length Polymorphism of the Internal Transcribed Spacer Region of the RDNA. Mem. Inst. Oswaldo Cruz 2016, 111, 267–270. [Google Scholar] [CrossRef][Green Version]
- Catrileo, D.; Acuña-Fontecilla, A.; Godoy, L. Adaptive Laboratory Evolution of Native Torulaspora delbrueckii YCPUC10 With Enhanced Ethanol Resistance and Evaluation in Co-Inoculated Fermentation. Front. Microbiol. 2020, 11, 3318. [Google Scholar] [CrossRef]
- Li, C.; Liu, Q.; Wang, Y.; Yang, X.; Chen, S.; Zhao, Y.; Wu, Y.; Li, L. Salt Stress Improves Thermotolerance and High-Temperature Bioethanol Production of Multi-Stress-Tolerant Pichia kudriavzevii by Stimulating Intracellular Metabolism and Inhibiting Oxidative Damage. Biotechnol. Biofuels 2021, 14, 222. [Google Scholar] [CrossRef]
- Park, H.J.; Bae, J.H.; Ko, H.J.; Lee, S.H.; Sung, B.H.; Han, J.I.; Sohn, J.H. Low-PH Production of d-Lactic Acid Using Newly Isolated Acid Tolerant Yeast Pichia kudriavzevii NG7. Biotechnol. Bioeng. 2018, 115, 2232–2242. [Google Scholar] [CrossRef]
- Pawlikowska, E.; James, S.A.; Breierova, E.; Antolak, H.; Kregiel, D. Biocontrol Capability of Local Metschnikowia Sp. Isolates. Antonie van Leeuwenhoek 2019, 112, 1425–1445. [Google Scholar] [CrossRef]
- Salvadó, Z.; Arroyo-López, F.N.; Guillamón, J.M.; Salazar, G.; Querol, A.; Barrio, E. Temperature Adaptation Markedly Determines Evolution within the Genus Saccharomyces. Appl. Environ. Microbiol. 2011, 77, 2292–2302. [Google Scholar] [CrossRef]
- Isono, N.; Hayakawa, H.; Usami, A.; Mishima, T.; Hisamatsu, M. A Comparative Study of Ethanol Production by Issatchenkia orientalis Strains under Stress Conditions. J. Biosci. Bioeng. 2012, 113, 76–78. [Google Scholar] [CrossRef] [PubMed]
- Matsushika, A.; Negi, K.; Suzuki, T.; Goshima, T.; Hoshino, T. Identification and Characterization of a Novel Issatchenkia orientalis GPI-Anchored Protein, IoGas1, Required for Resistance to Low PH and Salt Stress. PLoS ONE 2016, 11, e0161888. [Google Scholar] [CrossRef] [PubMed]
- Mukherjee, V.; Radecka, D.; Aerts, G.; Verstrepen, K.J.; Lievens, B.; Thevelein, J.M. Phenotypic Landscape of Non-Conventional Yeast Species for Different Stress Tolerance Traits Desirable in Bioethanol Fermentation. Biotechnol. Biofuels 2017, 10, 216. [Google Scholar] [CrossRef] [PubMed]
- Hernandez-Lopez, M.J.; Prieto, J.A.; Randez-Gil, F. Osmotolerance and Leavening Ability in Sweet and Frozen Sweet Dough. Comparative Analysis between Torulaspora delbrueckii and Saccharomyces cerevisiae Baker’s Yeast Strains. Antonie van Leeuwenhoek 2003, 84, 125–134. [Google Scholar] [CrossRef]
- Piraine, R.E.A.; Retzlaf, G.M.; Goncalves, V.S.; Cunha, R.C.; Leite, F.P.L. Brewing and Probiotic Potential Activity of Wild Yeasts Hanseniaspora uvarum PIT001, Pichia kluyveri LAR001 and Candida intermedia OEQ001. 2021. Available online: https://www.researchsquare.com/article/rs-772136/v1 (accessed on 18 December 2022).
- Ahangangoda Arachchige, M.S.; Yoshida, S.; Toyama, H. Thermo-and Salt-Tolerant Saccharomyces cerevisiae Strains Isolated from Fermenting Coconut Toddy from Sri Lanka. Biotechnol. Biotechnol. Equip. 2019, 33, 937–944. [Google Scholar] [CrossRef]
- Peña, A.; Sánchez, N.S.; Álvarez, H.; Calahorra, M.; Ramírez, J. Effects of High Medium PH on Growth, Metabolism and Transport in Saccharomyces cerevisiae. FEMS Yeast Res. 2015, 15, fou005. [Google Scholar] [CrossRef]
- Hadwiger, L.A.; McDonel, H.; Glawe, D. Wild Yeast Strains as Prospective Candidates to Induce Resistance Against Potato Late Blight (Phytophthora infestans). Am. J. Potato Res. 2015, 92, 379–386. [Google Scholar] [CrossRef]
- Douglass, A.P.; Offei, B.; Braun-Galleani, S.; Coughlan, A.Y.; Martos, A.A.R.; Ortiz-Merino, R.A.; Byrne, K.P.; Wolfe, K.H. Population Genomics Shows No Distinction between Pathogenic Candida krusei and Environmental Pichia kudriavzevii: One Species, Four Names. PLOS Pathog. 2018, 14, e1007138. [Google Scholar] [CrossRef]
- Nagarathnamma, T.; Chunchanur, S.K.; Rudramurthy, S.M.; Vineetha, K.R.; Ramamurthy, K.; Joseph, J.; Ambica, R. Outbreak of Pichia kudriavzevii Fungaemia in a Neonatal Intensive Care Unit. J. Med. Microbiol. 2017, 66, 1759–1764. [Google Scholar] [CrossRef]
- Wang, X.X.; Chi, Z.; Peng, Y.; Wang, X.H.; Ru, S.G.; Chi, Z.M. Purification, Characterization and Gene Cloning of the Killer Toxin Produced by the Marine-Derived Yeast Williopsis saturnus WC91-2. Microbiol. Res. 2012, 167, 558–563. [Google Scholar] [CrossRef]
- Magliani, W.; Conti, S.; Travassos, L.R.; Polonelli, L. From Yeast Killer Toxins to Antibiobodies and Beyond. FEMS Microbiol. Lett. 2008, 288, 1–8. [Google Scholar] [CrossRef] [PubMed][Green Version]
- Dukare, A.S.; Paul, S.; Nambi, V.E.; Gupta, R.K.; Singh, R.; Sharma, K.; Vishwakarma, R.K. Exploitation of Microbial Antagonists for the Control of Postharvest Diseases of Fruits: A Review. Crit. Rev. Food Sci. Nutr. 2018, 59, 1498–1513. [Google Scholar] [CrossRef] [PubMed]
- Ivanov, M.; Kannan, A.; Stojković, D.S.; Glamočlija, J.; Calhelha, R.C.; Ferreira, I.C.F.R.; Sanglard, D.; Soković, M. Flavones, Flavonols, and Glycosylated Derivatives—Impact on Candida albicans Growth and Virulence, Expression of CDR1 and ERG11, Cytotoxicity. Pharmaceuticals 2021, 14, 27. [Google Scholar] [CrossRef] [PubMed]
- Mayer, F.L.; Wilson, D.; Hube, B. Candida albicans Pathogenicity Mechanisms. Virulence 2013, 4, 119. [Google Scholar] [CrossRef]
- Csutak, O. Genetica Şi Biodiversitatea Drojdiilor Cu Aplicaţii Biotehnologice, București; Editura Universității din București: Bucharest, Romania, 2014. [Google Scholar]
- Ramos-Alonso, L.; Romero, A.M.; Martínez-Pastor, M.T.; Puig, S. Iron Regulatory Mechanisms in Saccharomyces cerevisiae. Front. Microbiol. 2020, 11, 2222. [Google Scholar] [CrossRef]
- Mažeika, K.; Šiliauskas, L.; Skridlaitė, G.; Matelis, A.; Garjonytė, R.; Paškevičius, A.; Melvydas, V. Features of Iron Accumulation at High Concentration in Pulcherrimin-Producing Metschnikowia Yeast Biomass. J. Biol. Inorg. Chem. 2021, 26, 299–311. [Google Scholar] [CrossRef]
- Hicks, R.H.; Moreno-Beltrán, M.; Gore-Lloyd, D.; Chuck, C.J.; Henk, D.A. The Oleaginous Yeast Metschnikowia pulcherrima Displays Killer Activity against Avian-Derived Pathogenic Bacteria. Biology 2021, 10, 1227. [Google Scholar] [CrossRef]
- Sipiczki, M. Metschnikowia pulcherrima and Related Pulcherrimin-Producing Yeasts: Fuzzy Species Boundaries and Complex Antimicrobial Antagonism. Microorganisms 2020, 8, 1029. [Google Scholar] [CrossRef]
- Manso, T.; Nunes, C. Metschnikowia andauensis as a New Biocontrol Agent of Fruit Postharvest Diseases. Postharvest Biol. Technol. 2011, 61, 64–71. [Google Scholar] [CrossRef]
- Parafati, L.; Vitale, A.; Restuccia, C.; Cirvilleri, G. Biocontrol Ability and Action Mechanism of Food-Isolated Yeast Strains against Botrytis cinerea Causing Post-Harvest Bunch Rot of Table Grape. Food Microbiol. 2015, 47, 85–92. [Google Scholar] [CrossRef]
- Oro, L.; Feliziani, E.; Ciani, M.; Romanazzi, G.; Comitini, F. Volatile Organic Compounds from Wickerhamomyces anomalus, Metschnikowia pulcherrima and Saccharomyces cerevisiae Inhibit Growth of Decay Causing Fungi and Control Postharvest Diseases of Strawberries. Int. J. Food Microbiol. 2018, 265, 18–22. [Google Scholar] [CrossRef] [PubMed]
- Kameri, A.; Koçani, F.; Hashani, Z.; Kurteshi, K.; Kamberi, B.; Kurti, A.; Haziri, A. Antifungal and Synergistic Effects of the Ethyl Acetate Extract of Tanacetum vulgare (L.) Against Candida albicans. Med. Sci. Monit. Basic Res. 2019, 25, 179. [Google Scholar] [CrossRef] [PubMed]
- Lopes, C.A.; Sangorrín, M.P. Optimization of Killer Assays for Yeast Selection Protocols. Rev. Argent. Microbiol. 2010, 42, 298–306. [Google Scholar] [CrossRef] [PubMed]
- Büyüksırıt-Bedir, T.; Kuleaşan, H. Purification and Characterization of a Metschnikowia pulcherrima Killer Toxin with Antagonistic Activity against Pathogenic Microorganisms. Arch. Microbiol. 2022, 204, 337. [Google Scholar] [CrossRef]
- Bajaj, B.K.; Raina, S.; Singh, S. Killer Toxin from a Novel Killer Yeast Pichia kudriavzevii RY55 with Idiosyncratic Antibacterial Activity. J. Basic Microbiol. 2013, 53, 645–656. [Google Scholar] [CrossRef] [PubMed]
- Rodríguez, M.E.; Pérez-Través, L.; Sangorrín, M.P.; Barrio, E.; Querol, A.; Lopes, C.A. Saccharomyces uvarum Is Responsible for the Traditional Fermentation of Apple Chicha in Patagonia. FEMS Yeast Res. 2017, 17, fow109. [Google Scholar] [CrossRef] [PubMed]
- Orentaite, I.; Poranen, M.M.; Oksanen, H.M.; Daugelavicius, R.; Bamford, D.H. K2 Killer Toxin-Induced Physiological Changes in the Yeast Saccharomyces cerevisiae. FEMS Yeast Res. 2016, 16, fow003. [Google Scholar] [CrossRef] [PubMed]
- Becker, B.; Schmitt, M.J. Yeast Killer Toxin K28: Biology and Unique Strategy of Host Cell Intoxication and Killing. Toxins 2017, 9, 333. [Google Scholar] [CrossRef] [PubMed]
- Rodríguez-Cousiño, N.; Esteban, R. Relationships and Evolution of Double-Stranded RNA Totiviruses of Yeasts Inferred from Analysis of L-A-2 and L-BC Variants in Wine Yeast Strain Populations. Appl. Environ. Microbiol. 2017, 83, 2991–3007. [Google Scholar] [CrossRef]
- Rodríguez-Cousiño, N.; Maqueda, M.; Ambrona, J.; Zamora, E.; Esteban, R.; Ramírez, M. A New Wine Saccharomyces cerevisiae Killer Toxin (Klus), Encoded by a Double-Stranded RNA Virus, with Broad Antifungal Activity Is Evolutionarily Related to a Chromosomal Host Gene. Appl. Environ. Microbiol. 2011, 77, 1822–1832. [Google Scholar] [CrossRef]
- Renault, P.; Miot-Sertier, C.; Marullo, P.; Hernández-Orte, P.; Lagarrigue, L.; Lonvaud-Funel, A.; Bely, M. Genetic Characterization and Phenotypic Variability in Torulaspora delbrueckii Species: Potential Applications in the Wine Industry. Int. J. Food Microbiol. 2009, 134, 201–210. [Google Scholar] [CrossRef] [PubMed]
- Mehlomakulu, N.N.; Setati, M.E.; Divol, B. Characterization of Novel Killer Toxins Secreted by Wine-Related Non-Saccharomyces Yeasts and Their Action on Brettanomyces Spp. Int. J. Food Microbiol. 2014, 188, 83–91. [Google Scholar] [CrossRef] [PubMed]
- Villalba, M.L.; Susana Sáez, J.; del Monaco, S.; Lopes, C.A.; Sangorrín, M.P. TdKT, a New Killer Toxin Produced by Torulaspora delbrueckii Effective against Wine Spoilage Yeasts. Int. J. Food Microbiol. 2016, 217, 94–100. [Google Scholar] [CrossRef] [PubMed]

| Conventional Tests | MD3 | M1 | M3 | M5 | MS1-1 | |
|---|---|---|---|---|---|---|
| Ascopores | Non-fermentative carbon sources (10% CaCO3 Agar | + | - | - | - | + |
| 5% Malt agar | NT | + | - | + | NT | |
| Urease | Christensen’s Urea Agar +0.1% glucose | - | - | + | - | - |
| Difco Urea Broth | NT | NT | - | NT | NT | |
| Cycloheximide | 0.01% | - | W | - | - | - |
| 0.1% | - | - | - | - | - | |
| Temperature | 20 °C | + | + | + | + | + |
| 28 °C | + | + | + | + | + | |
| 37 °C | + | W | + | + | + | |
| 42 °C | + | - | - | - | + | |
| Osmotic stress | Glucose 50% | + | + | + | + | + |
| Glucose 60% | + | + | + | + | + | |
| Carbon aerobic assimilation tests | D-Glucose | + | + | + | + | + |
| D-galactose | W | - | + | - | - | |
| Xylitol | - | - | + | - | - | |
| Raffinose | - | - | - | - | W | |
| Nitrogen assimilation tests | L-lysine | - | + | + | + | - |
| Potassium nitrate | - | - | - | - | - | |
| Sodium nitrite | - | - | - | - | - | |
| Ammonium sulphate | + | + | + | + | + | |
| Biolog Microbial ID System (Figure S1) | S. boulardii | No id | M. pulcherrima | No id | S. cerevisiae | |
| Bruker Maldi-TOF MS | S. cerevisiae | H. uvarum | M. pulcherrima | No id | S. cerevisiae | |
| Conventional Tests | S. cerevisiae CBS380 | H. uvarum CBS279 | M. pulcherrima CBS5534 | T. delbrueckii CBS133 | |
|---|---|---|---|---|---|
| Ascospores | Non-fermentative carbon sources (10% CaCO3 Agar/Acetate agar) | + | NT | NT | NT |
| 5% Malt Agar | + | - | + | ||
| Urease | - | - | - | - | |
| Cycloheximide | 0.01% | - | + | - | - |
| 0.1% | - | +/- | - | - | |
| Temperature | 20 °C | + | + | + | + |
| 28 °C | + | + | + | + | |
| 37 °C | +/- | - | - | +/- | |
| 42 °C | +/- | - | - | - | |
| Osmotic stress | Glucose 50% | +/- | +/- | +/- | + |
| Glucose 60% | - | - | +/- | +/- | |
| Carbon aerobic assimilation tests | D-Glucose | + | + | + | + |
| D-galactose | +/- | - | + | +/- | |
| Xylitol | - | - | + | +/- | |
| Raffinose | +/- | - | - | +/- | |
| Nitrogen assimilation tests | L-lysine | - | + | + | + |
| Potassium nitrate | - | - | - | - | |
| Sodium nitrite | - | - | - | +/- | |
| Ammonium sulphate | + | + | + | + | |
| Isolate | Amplicon (bp) | CfoI (bp) | HaeIII (bp) | HinfI (bp) | MspI (bp) | Reference |
|---|---|---|---|---|---|---|
| MD3 | 850 | 135; 350; 350 | 135; 175; 225; 325 | 135; 350; 350 | 130; 700 | |
| MS1-1 | 850 | 140; 350; 350 | 135; 175; 20; 320 | 135; 350; 350 | 130; 700 | |
| S. cerevisiae | 850 | nd | nd | nd | 130; 740 | [43] |
| S. cerevisiae | 860 | nd | nd | 125; 370 | nd | [44] |
| S. cerevisiae | 880 | nd | 150; 180; 230; 320 | 155; 365 | nd | [45] |
| S. cerevisiae | 880 | nd | 150; 180; 240; 310 | 40; 120; 350 | 120; 750 | [46] |
| S. cerevisiae | 880 | 365; 385 | 130; 180; 230; 320 | 180; 350; 360 | nd | [47] |
| S. cerevisiae | 850 | 150; 325; 375 | 125; 230; 495 | 110; 365; 375 | nd | [48] |
| M5 | 775 | 100; 150; 225; 350 | 750 | 375; 400 | 775 | |
| T. delbrueckii | 798 | 102; 139; 220; 327 | 800 | 160; 190; 360 | nd | [49] |
| T. delbrueckii | 800 | 100; 150; 220; 330 | 798 | 380; 410 | nd | [49] |
| M3 | 390 | 100; 200 | 100; 290 | 190; 200 | 50; 120; 210 | |
| M. pulcherrima | 390 | 100; 210 | 100; 285 | 190; 200 | nd | [50] |
| M1 | 725 | 100; 315; 320 | 715 | 65; 135; 160; 325 | 715 | |
| H. uvarum CBS 314 | 745 | 105; 315; 324 | 747 | 62; 155; 188; 342 | nd | [49] |
| H. uvarum CECT 1444 | 760 | 105; 315; 320 | 760 | 180; 200; 360 | nd | [49] |
| H. uvarum NCYC2739 | 750 | 105; 310; 320 | 750 | 180; 200; 350 | nd | [49] |
| H. uvarum CBS 104 | 745 | 105; 315; 324 | 745 | 70; 150; 180; 330 | nd | [49] |
| Isolates | Caseinase | Amilase | Gelatinase | Hemolysine | Phospholipase | Siderophore-like Compounds | DN-Ase |
|---|---|---|---|---|---|---|---|
| H. uvarum CMGB-M1 | - | - | - | - | - | + | - |
| M. pulcherrima CMGB-M3 | W | + | - | - | - | + | D |
| T. delbrueckii CMGB-M5 | - | + | - | - | - | D | - |
| P. kudriavzevii CMGB-M6 | - | + | - | - | - | - | + |
| S. cerevisiae CMGB-MD3 | - | - | - | - | - | - | - |
| S. cerevisiae CMGB-MS1-1 | - | + | - | - | - | - | - |
| Isolates | C. parapsilosis CBS 604 | C. parapsilosis CMGBY3 | C. krusei CMGB 94 | C. krusei CMGB-Y8 | C. albicans ATCC10231 | |
|---|---|---|---|---|---|---|
| H. uvarum CMGB-M1 | 3 days | - | - | - | - | - |
| 7 days | - | - | - | - | - | |
| M. pulcherrima CMGB-M3 | 3 days | + | - | + | - | - |
| 7 days | + | - | + | - | ++ | |
| T. delbrueckii CMGB-M5 | 3 days | - | - | - | - | - |
| 7 days | - | - | - | - | - | |
| P. kudriavzevii CMGB-M6 | 3 days | - | - | - | - | - |
| 7 days | - | - | - | - | - | |
| S. cerevisiae CMGB-MD3 | 3 days | - | - | - | - | - |
| 7 days | - | - | - | - | - | |
| S. cerevisiae CMGB-MS1-1 | 3 days | - | - | - | - | - |
| 7 days | - | - | - | - | - | |
| Isolates | C. parapsilosis CBS 604 | C. parapsilosis CMGBY3 | C. krusei CMGB94 | C. krusei CMGB Y8 | C. albicans ATCC 10231 | |||||
|---|---|---|---|---|---|---|---|---|---|---|
| 3 Days | 7 Days | 3 Days | 7 Days | 3 Days | 7 Days | 3 Days | 7 Days | 3 Days | 7 Days | |
| H. uvarum CMGB-M1 | - | - | - | - | - | - | - | - | - | - |
| M. pulcherrima CMGB-M3 | - | - | - | + | + | ++ | ++ | ++ | + | + |
| T. delbrueckii CMGB-M5 | - | - | - | - | + | - | ++ | + | - | - |
| S. cerevisiae CMGB-MD3 | + | - | - | - | + | +++ | ++ | ++ | + | - |
| S. cerevisiae CMGB-MS1-1 | - | - | - | - | - | - | - | - | - | - |
| P. kudriavzevii CMGB-M6 | + | - | - | - | - | - | - | - | - | - |
Disclaimer/Publisher’s Note: The statements, opinions and data contained in all publications are solely those of the individual author(s) and contributor(s) and not of MDPI and/or the editor(s). MDPI and/or the editor(s) disclaim responsibility for any injury to people or property resulting from any ideas, methods, instructions or products referred to in the content. |
© 2022 by the authors. Licensee MDPI, Basel, Switzerland. This article is an open access article distributed under the terms and conditions of the Creative Commons Attribution (CC BY) license (https://creativecommons.org/licenses/by/4.0/).
Share and Cite
Corbu, V.M.; Csutak, O. Molecular and Physiological Diversity of Indigenous Yeasts Isolated from Spontaneously Fermented Wine Wort from Ilfov County, Romania. Microorganisms 2023, 11, 37. https://doi.org/10.3390/microorganisms11010037
Corbu VM, Csutak O. Molecular and Physiological Diversity of Indigenous Yeasts Isolated from Spontaneously Fermented Wine Wort from Ilfov County, Romania. Microorganisms. 2023; 11(1):37. https://doi.org/10.3390/microorganisms11010037
Chicago/Turabian StyleCorbu, Viorica Maria, and Ortansa Csutak. 2023. "Molecular and Physiological Diversity of Indigenous Yeasts Isolated from Spontaneously Fermented Wine Wort from Ilfov County, Romania" Microorganisms 11, no. 1: 37. https://doi.org/10.3390/microorganisms11010037
APA StyleCorbu, V. M., & Csutak, O. (2023). Molecular and Physiological Diversity of Indigenous Yeasts Isolated from Spontaneously Fermented Wine Wort from Ilfov County, Romania. Microorganisms, 11(1), 37. https://doi.org/10.3390/microorganisms11010037

